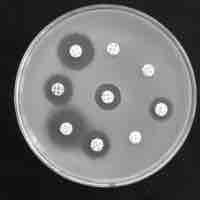
Thumbnail

Section 1
Biotechnology
By Boundless

Relying on the study of DNA, genomics analyzes entire genomes, while biotechnology uses biological agents for technological advancements.

Basic techniques used in genetic material manipulation include extraction, gel electrophoresis, PCR, and blotting methods.

Molecular cloning reproduces the desired regions or fragments of a genome, enabling the manipulation and study of genes.

Reproductive cloning, possible through artificially-induced asexual reproduction, is a method used to make a clone of an entire organism.

In genetic engineering, an organism's genotype is altered using recombinant DNA, created by molecular cloning, to modify an organism's DNA.

Transgenic modification, adding recombinant DNA to a species, has led to the expression of desirable genes in plants and animals.

From manipulation of mutant genes to enhanced resistance to disease, biotechnology has allowed advances in medicine.
Biotechnological advances in gene manipulation techniques have further resulted in the production of vaccines, antibiotics, and hormones.